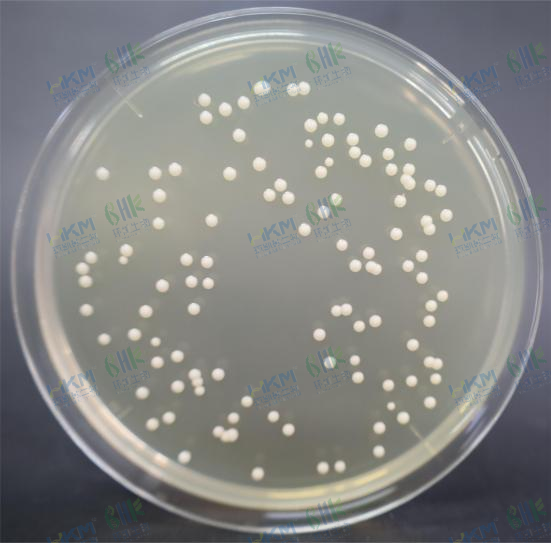
白色念珠菌CMCC(F)98001
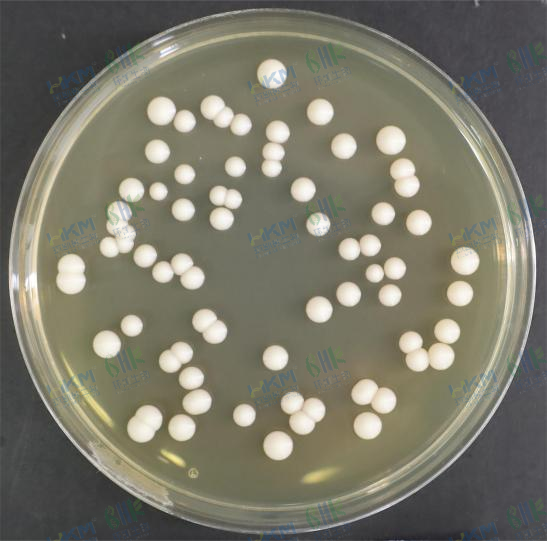
酿酒酵母CMCC(F)98018
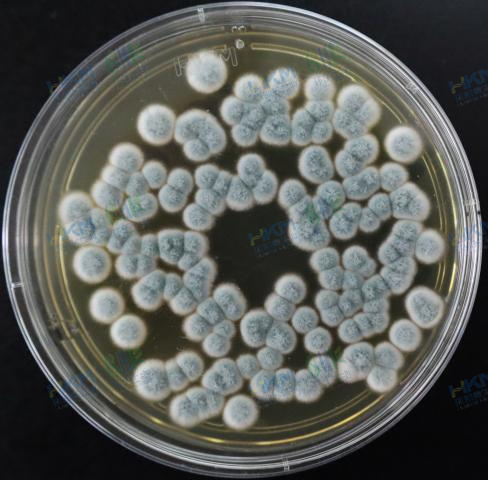
桔青霉CMCC(F)98028
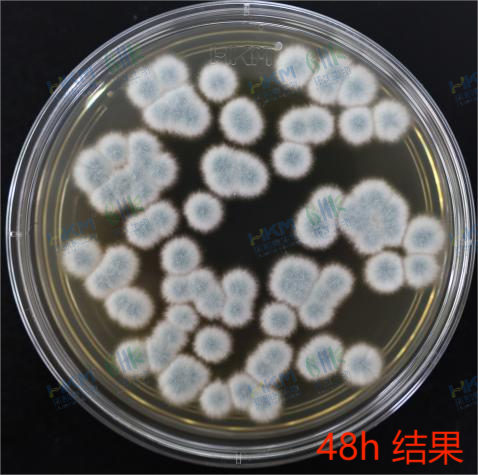
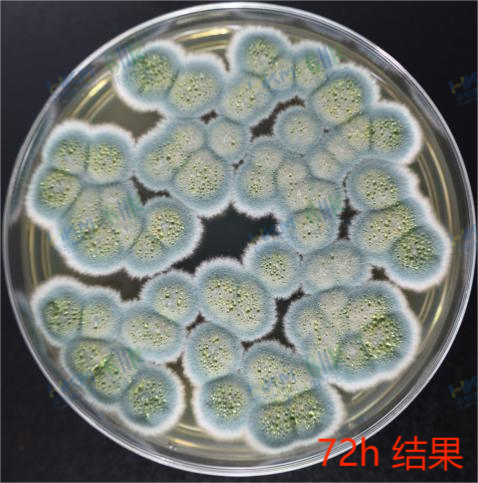
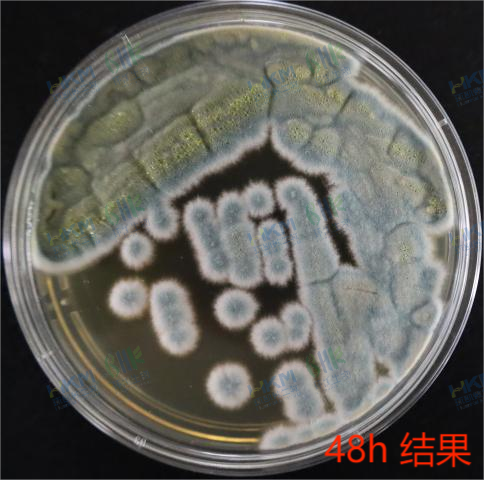

GB4789.28—2024参比培养基质控解析及图谱—SDA篇
发布时间:2025-05-08 浏览次数:3038
前面已经与大家分享了TSA参比培养基的质控解析及相应的图谱,同样,SDA参比培养基在国标GB4789.28中对酵母菌、霉菌培养用的培养基质控有着同等重要地位,今天大家就跟随小编的脚步一起来看一下作为参比培养基的SDA,其质控解析及相应图谱吧!
沙氏葡萄糖琼脂(Sabouraud Dextrose Agar Medium,SDA)参比培养基,其质控分四步走。
第一,核对配方成分,应与标准一致。即符合如下表配方:
| 蛋白胨 | 5.0g |
| 酪蛋白胨 | 5.0g |
| 葡萄糖 | 40.0g |
| 琼脂 | 15.0g |
第二,使用者审核参比培养基检测报告,是否由具备相应检验能力,并取得通过国家认证认可资质检验机构出具的检测报告。
第三,理化指标应满足的条件如下:
① 肉眼观察,并记录干燥培养基粉末颜色:淡黄色粉末。
② 灭菌后溶液颜色、透明度:灭菌后为淡黄色透明胶体。
③ PH测试,121℃高压灭菌15min后,倾倒平板,待凝固平衡至25℃时测定,应为5.6±0.2℃。
④ 凝胶强度测试,SDA培养基制成平板或斜面,冷凝后用10μL接种环在其上划线,普通平板可采用三区/四区划线法,斜面采用之字形划线法,观察划线过程中的破裂情况,要求划线不破。
第四,最最关键的微生物学促生长能力,应满足在规定的培养和时间内,生长良好且符合相应的菌落形态特征。

微生物学促生长能力试验方法参照下面方法:
Step1、将白色念珠菌、酿酒酵母接种到非选择性液体培养基(如沙氏葡萄糖液体培养基、马铃薯葡萄糖液体培养基等)培养或使用非选择性培养基平板/斜面(普通SDA、PDA等)进行培养。将培养后浑浊的菌液进行10倍系列稀释。平板或斜面菌苔则刮取一定量进行稀释(这种操作很大程度依赖于检验员的经验)。黑曲霉、桔青霉、产黄青霉接种于装有上述琼脂培养基的罗氏瓶或者较粗试管中,铺成斜面,进行涂布或划线,培养过程中保持良好的透气性,且不污染环境,进行培养,直至长出丰富的孢子。将孢子进行洗脱,之后进行10倍系列稀释。选取适宜的稀释级(要求酵母菌每0.1ml菌含量50—250cfu,霉菌每0.1ml菌液其菌含量在30—150cfu)。
Step2、选择适宜稀释度的工作菌悬液0.1mL,涂布或螺旋接种于测试平板上,每稀释度做两个平板。按标准规定的条件培养,观察并记录。
为了让大家更形象直观的看到以上五种菌在SDA参比培养基上的具体形态,小编使用环凯自主研发生产的SDA参比培养基,测试菌株在SDA参比培养基上的高清无码图见下表(以下图片均为环凯原创,转载或引用请注明出处)
附表:测试菌株在SDA参比培养基上的菌落形态
| 菌株名称及编号 | 培养条件 | 接种量/cfu | 菌落特征图 | 实验结果 |
|---|---|---|---|---|
| 黑曲霉CMCC(F)98003 | 28℃,72h | 40 |  | 生长良好,白色菌丝,黑色孢子 |
| 白色念珠菌CMCC(F)98001 | 28℃,72h | 113 | | 生长良好,白色圆形菌落 |
| 酿酒酵母CMCC(F)98018 | 28℃,72h | 72 | | 生长良好,奶油色圆形菌落 |
| 桔青霉CMCC(F)98028 | 28℃,72h | 141 | | 生长良好,白色菌丝,绿色孢子 |
| 产黄青霉CMCC(F)98801 | 28℃,72h | 67 | | 生长良好,白色菌丝,绿色孢子 |
| ||||
|






